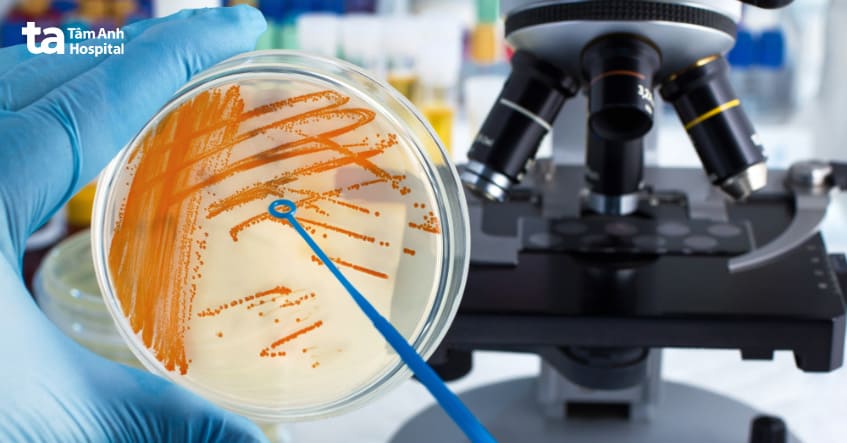
chẩn đoán bằng cách xét nghiệm nuôi cấy nước tiểu

Nhiễm trùng tiểu không triệu chứng phổ biến khi có trên 15% phụ nữ và nam giới từ 65 – 80 tuổi mắc bệnh, người sau 80 tuổi con số này có thể lên đến 40% – 50%.

Nhiễm trùng tiểu không triệu chứng là sự hiện diện của vi khuẩn trong nước tiểu khi mang đi xét nghiệm, người bệnh mặc dù có nhiễm trùng nhưng không có dấu hiệu hoặc triệu chứng của nhiễm trùng đường tiết niệu. Tình trạng nhiễm trùng tiểu không có triệu chứng là rất phổ biến, có tên gọi chính xác là “Vi khuẩn không có triệu chứng – Asymptomatic bacteriuria”.
Nhiễm trùng đường tiểu không triệu chứng có thể xuất hiện ở bất kỳ ai, từ trẻ sơ sinh và trẻ mới biết đi, tỷ lệ mắc tăng theo tuổi. Tỷ lệ mắc bệnh lên tới 15%, thậm chí có thể cao hơn ở phụ nữ và nam giới từ 65 – 80 tuổi; tỷ lệ này cao tới 40% – 50% với người sau 80 tuổi.(1)
Hầu hết người mắc tình trạng này sẽ không phát triển thành nhiễm trùng tiểu có triệu chứng và không gặp biến chứng. Hiện, nhiễm trùng tiểu không triệu chứng cũng không được điều trị bằng kháng sinh và việc điều trị gần như không có ý nghĩa đối với hầu hết người bệnh. Tuy nhiên, có một vài ngoại lệ, như phụ nữ mang thai bị nhiễm trùng tiểu không có triệu chứng có thể cần phải điều trị.
Nhiễm trùng tiểu không triệu chứng không phải UTIs. Vì vi khuẩn không có triệu chứng (Asymptomatic bacteriuria) trong nhiễm trùng tiểu không triệu chứng không giống như nhiễm trùng đường tiết niệu (UTI), mặc dù cả 2 đều có liên quan đến vi khuẩn.
Vi khuẩn không có triệu chứng liên quan đến sự hiện diện của vi khuẩn trong nước tiểu mà không có bất kỳ dấu hiệu hoặc triệu chứng nhiễm trùng nào. Còn nhiễm trùng đường tiết niệu bất kỳ, được chẩn đoán khi người bệnh có cả 2 yếu tố là có vi khuẩn trong nước tiểu và các triệu chứng của nhiễm trùng như: sốt, cảm giác nóng rát hoặc đi tiểu thường xuyên.

Nhiễm khuẩn tiết niệu không triệu chứng là phát hiện lâm sàng phổ biến. Trong khi ít hơn 0,5% trẻ sơ sinh và trẻ mới biết đi có nhiễm trùng tiểu không có triệu chứng, tỷ lệ mắc tăng theo tuổi. Tỷ lệ mắc là 5% hoặc ít hơn ở phụ nữ tiền mãn kinh khỏe mạnh, lên tới 15% hoặc lớn hơn ở phụ nữ và nam giới từ 65 – 80 tuổi, và tỷ lệ này tiếp tục tăng sau 80 tuổi (40% – 50%).
Ở mọi lứa tuổi, tỷ lệ mắc vi khuẩn không có triệu chứng cao hơn ở nữ giới so với nam giới. Escherichia coli (E.coli) là vi khuẩn phổ biến được xác định trong nhiễm trùng tiểu không triệu chứng.
Người bị nhiễm trùng tiểu không có triệu chứng, theo định nghĩa là họ không có bất kỳ biểu hiện hay triệu chứng gì cho thấy có sự hiện diện của vi khuẩn trong nước tiểu. Càng không có triệu chứng có thể được quy cho vi khuẩn trong nước tiểu ví dụ như sốt, mệt mỏi, buồn nôn,… Điều này hoàn toàn khác với nhiễm vi khuẩn triệu chứng hoặc nhiễm trùng đường tiết niệu.
Nguyên nhân của nhiễm khuẩn tiết niệu không triệu chứng hiện vẫn chưa được xác định. Vi khuẩn không có triệu chứng phổ biến ở phụ nữ, với tỷ lệ mắc cao hơn ở nam giới, có lẽ là do niệu đạo nữ ngắn hơn, tạo điều kiện vi khuẩn từ niệu đạo và hậu môn di chuyển đến bàng quang.
Trên thực tế, hầu hết phụ nữ đều mắc nhiễm trùng đường tiết niệu tối thiểu 1 lần sau khi quan hệ tình dục, nhưng rất ít phụ nữ này sẽ bị nhiễm trùng triệu chứng vì cơ chế phòng thủ bình thường của cơ thể ngăn ngừa nhiễm trùng triệu chứng trong hầu hết các trường hợp. Ở người cao tuổi, người ta cho rằng việc làm trống bàng quang không hoàn toàn (bí tiểu mạn tính) góp phần tăng tỷ lệ mắc nhiễm khuẩn tiết niệu không triệu chứng.
Chẩn đoán nhiễm trùng đường tiết niệu không triệu chứng được thực hiện bằng xét nghiệm nuôi cấy nước tiểu. Trong đó, mẫu thử (nước tiểu) sẽ được thu thập đúng cách hoặc lấy nước tiểu từ đặt ống thông. Hiệp hội bệnh truyền nhiễm Hoa Kỳ (IDSA) đã thiết lập các tiêu chí để chẩn đoán vi khuẩn không có triệu chứng như sau:
Kết quả xét nghiệm nuôi cấy này, người bệnh sẽ được kết luận mắc nhiễm trùng tiểu không triệu chứng.
Phụ nữ mang thai nên được sàng lọc vi khuẩn không có triệu chứng với nuôi cấy nước tiểu. Thời gian tối ưu và tần suất của nuôi cấy nước tiểu trong thai kỳ vào cuối 3 tháng đầu của thai kỳ (cuối tam cá nguyệt thứ nhất). Riêng với những người đang trải qua hoặc hồi phục sau các thủ thuật ngoại khoa, can thiệp vào đường tiết niệu gây chảy máu niêm mạc, như cắt bỏ tuyến tiền liệt và người bệnh trong 3 tháng đầu sau khi ghép thận có thể cần xét nghiệm khác để chẩn đoán nhiễm trùng tiểu không triệu chứng.
Hầu hết các trường hợp bị vi khuẩn không có triệu chứng sẽ không bị nhiễm trùng đường tiết niệu có triệu chứng và sẽ không bị ảnh hưởng sức khỏe bởi vi khuẩn không có triệu chứng. Cụ thể, trẻ em, người mắc bệnh tiểu đường, người lớn tuổi, bị chấn thương tủy sống và người đang sử dụng ống thông tiểu không cần điều trị bằng kháng sinh đối với vi khuẩn không có triệu chứng.
Vì điều trị ở những trường hợp này không làm giảm tỷ lệ nhiễm trùng đường tiết niệu có triệu chứng hoặc cải thiện khả năng sống sót. Ngược lại, có thể làm tăng khả năng tác dụng phụ từ kháng sinh và sự phát triển của vi khuẩn kháng kháng sinh.
Ngược lại, có một số trường hợp bắt buộc phải điều trị như: phụ nữ mang thai bị vi khuẩn không có triệu chứng. Điều trị bằng thuốc chống vi khuẩn cho vi khuẩn không có triệu chứng trong thai kỳ làm giảm nguy cơ viêm bể thận, trẻ sơ sinh nhẹ cân và sinh non. Ngoài ra, những người đang trải qua các thủ thuật tiết niệu gây chảy máu niêm mạc, như cắt bỏ tuyến tiền liệt và người ghép thận trong 3 tháng đầu cũng cần được điều trị.
Việc điều trị vi khuẩn không có triệu chứng ở những trường hợp này làm giảm nguy cơ nhiễm trùng đường tiết niệu triệu chứng. Phác đồ điều trị dựa trên kết quả nuôi cấy nước tiểu và độ nhạy của xét nghiệm. Amoxicillin, amoxicillin/clavulanate, cefuroxime, cephalexin và nitrofurantoin được coi là an toàn để sử dụng trong thai kỳ. Thời gian điều trị nên trong 3 – 7 ngày đối với phụ nữ mang thai, nên thực hiện tối thiểu 1 lần nuôi cấy nước tiểu theo dõi trong suốt phác đồ.
Nhiễm khuẩn đường tiết niệu không triệu chứng có thể phòng ngừa được bằng cách phòng ngừa UTI để làm giảm nguy cơ phát triển nhiễm khuẩn không triệu chứng. Các chiến lược phòng ngừa bao gồm:
Khám sức khỏe tiết niệu định kỳ để phát hiện sớm các vấn đề về sức khỏe, nhiễm trùng đường tiết niệu và các vấn đề về sỏi khác tại khoa Tiết niệu, Trung tâm Tiết niệu – Thận học – Nam khoa, BVĐK Tâm Anh TP.HCM và Đơn vị Tiết niệu, Trung tâm Khám chữa bệnh Tâm Anh Quận 7. Tại đây người bệnh sẽ được chẩn đoán toàn diện và điều trị hiệu quả theo phác đồ cá nhân, riêng biệt.
HỆ THỐNG BỆNH VIỆN ĐA KHOA TÂM ANH
Nhiễm trùng tiểu không triệu chứng là tình trạng phổ biến, không nguy hiểm trong hầu hết các trường hợp và không cần điều trị bằng kháng sinh. Tuy nhiên, phụ nữ mang thai và người can thiệp tiết niệu cần được sàng lọc kỹ lưỡng. Nếu bạn có kết quả nước tiểu bất thường, hãy đến khám tại các chuyên khoa Tiết niệu để được chẩn đoán và tư vấn phù hợp.